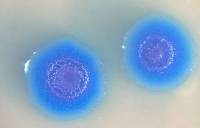

Că viața obișnuită nu este periculos și este ușor tratabile, în timpul sarcinii poate fi o amenințare uriașă - pentru mame viitoare, precum și pentru dezvoltarea copilului in uter. Una dintre aceste infecții este micoplasmoze - de asemenea, numit Mycoplasma.
Micoplasmoze - boala cauzata de Mycoplasma la om. Este o încrucișare între bacterii, ciuperci și virusuri, acestea sunt paraziți pe celulele organismului, produse din acesta substanțele nutritive și, prin urmare, nu poate exista pe cont propriu. Micoplasme sunt atașate la celule epiteliale: doar patru tipuri de ele pot provoca boli. Mycoplasma pneumonia - afecteaza sistemul respirator, bacteriile cauzează inflamația gâtului, tuburi și plămânii bronsice. Mycoplasma genitalium, Mycoplasma hominis, Ureaplasma urealiticum - agenții cauzatori ai Mycoplasma urogenitale, care este cel mai adesea cu transmitere sexuala.
În corpul de Mycoplasma - formă de serpentină alungită. Ea părea să fie înșurubate între celulele corpului la care este atașat, și, prin urmare, încalcă activitatea lor. Cu toate acestea, modul în care acestea provoacă boala - experții încă nu au dat seama.
În mediul extern Mycoplasma pieri repede, dar cu toate acestea, „planta“ ei le pot fi de contact intern sau sexuală. De exemplu, pentru a măsura lenjerie de corp după străin, străin șters cu un prosop.
Simptomele de Mycoplasma nu este de ajuns - are loc ascuns și, de fapt, jumatate din pacientii cu boala nu se simt. Din același motiv, pentru a diagnostica Mycoplasma este destul de dificil. În plus, micoplasme sunt foarte mici: acestea sunt practic imposibil de detectat prin microscopie. Micoplasmoze detectată prin eșantionare tampoane prin reacția în lanț a polimerazei (PCR se numește diagnosticare ADN) sau prin imunofluorescență.
In timpul sarcinii mycoplasma exacerbat, ceea ce duce la complicații, dar pentru că - se îmbolnăvesc foarte periculos în acest moment. Experții spun că Mycoplasma este direct legat de avort spontan și de sarcină „non-viabile“.
Rar micoplasme nu afectează fătul, dar crește foarte mult riscul de nastere prematura. Acesta protejează copilul de placenta infecției, dar procesul inflamator cauzate de Mycoplasma, este foarte periculos, deoarece peretii vaginali si colul uterin se pot deplasa la membranele. Acestea, la rândul lor, se pot sparge, apoi se îndepărteze amniotic munca fluid și prematura va începe.
În cazul în care infecția cu Mycoplasma este prea activ, atunci sarcina este complicatii speciale: posibile polyhydramnios. atașarea necorespunzătoare a placentei, complicații post-partum in mama, patologia sistemului urinar al mamei.
Frecvența infectiei fetale cu boala micoplasmozei până la 20%. În cazul în care o boală gravă poate fi rinichii afectati, ficatul, sistemul nervos, ochii, pielea, ganglionii limfatici. Mycoplasma fatului poate actiona la nivel genetic.
Dar toate aceste complicatii se dezvolta numai în cazul în care boala în faza activă, în cazul în care un operator de transport numai gravidă de infecție, medicul recomandă ca ea doar efectua în mod constant infecție a culturilor.
Se tratează mycoplasma în al doilea trimestru de sarcină. Prevăzută ca regulă, antibiotice și imunostimulator. Tratamentul se efectuează numai cu partenerul sexual, în caz contrar re-infectie este inevitabilă, pentru că nu există nici o rezistență la boli.
Special dlyaberemennost.net - Mariya Dulina